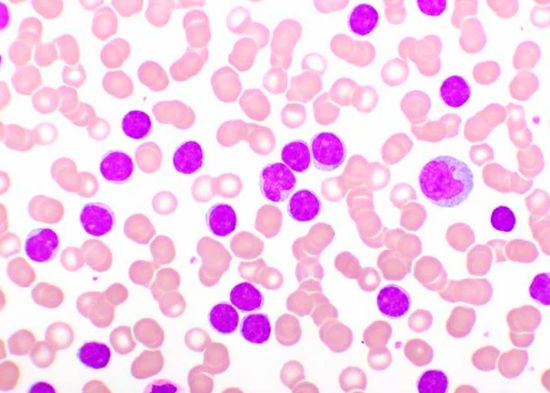

La OPEP presenta panorama desalentador sobre petróleo
Viena, Austria.-La Organización de Países Exportadores de Petróleo (OPEP) considera que existe margen para un crecimiento mayor de la demanda petrolera en 2022 debido a la fuerte reactivación económica, que ya ha llevado el crudo a cotizar por encima de los 90 dólares el barril.
Leer más…La OPEP presenta panorama desalentador sobre petróleo